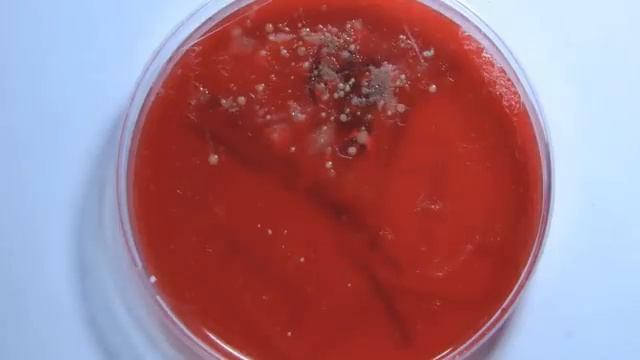
Metro Exodus Worm Explored | Novosibirsk Leech Morphology and Tunnel Explained | Lore Analysis смотреть онлайн

Автор / Канал: Скрытые миссии игры Страница 8

Grand Vegas Crime-18-Super Mafia City Gangster Gameplay 2023-Open World Game for Android-HEROLOW

Chicago 1949 ROBLOX |FERNANDO'S FAMILY| THE LIFE OF MAFIA
![Tech Itch and Jakes - Life of Sin (GEIN plungecore edit) [FREE MP3] смотреть онлайн Tech Itch and Jakes - Life of Sin (GEIN plungecore edit) [FREE MP3] смотреть онлайн](https://pic.rtbcdn.ru/video/2024-10-29/a7/f6/a7f6d2d088204c98dc57c93491525dd0.jpg)
Tech Itch and Jakes - Life of Sin (GEIN plungecore edit) [FREE MP3]

max payne 2 demo free download

The Sacrifice Is Bill! | Left 4 Dead 2

Let's Play Deathcraft II-(L4D2 Mod) S05 Starring Jahara Mushroom Biome End
![[FREE] Ice Cube westcoast type beat "FRIDAY" (prod by Baluface) смотреть онлайн [FREE] Ice Cube westcoast type beat "FRIDAY" (prod by Baluface) смотреть онлайн](https://pic.rtbcdn.ru/video/2024-10-28/28/57/2857d750c5c5525bd92fde931fc0097f.jpg)
[FREE] Ice Cube westcoast type beat "FRIDAY" (prod by Baluface)

SSE- SCVI Nightmare - Armor & Weapon Pack 2.0.0

Max Payne 3 - (Valve Steam Deck) - Framerate & Gameplay

Mafia 2 - Multiplayer CZ
![Duo Expert Be Like [Left 4 Dead 2] смотреть онлайн Duo Expert Be Like [Left 4 Dead 2] смотреть онлайн](https://pic.rtbcdn.ru/video/2024-10-30/11/50/1150303c069e71401c7e1b938cfe8da5.jpg)
Duo Expert Be Like [Left 4 Dead 2]

swedish house mafia don´t you worry child ft. john martin cover trumpet version Ruben Hernandez

Gangster Music ❃ New Remix Turkish Trap Music Mafia SQUAD

Top FashionNova Picks
Metro Exodus Worm Explored | Novosibirsk Leech Morphology and Tunnel Explained | Lore Analysis
![First video[Halo looking sus POV ] смотреть онлайн First video[Halo looking sus POV ] смотреть онлайн](https://pic.rtbcdn.ru/video/2024-10-30/f2/97/f2974fe2466282b8895119b2ceaf219b.jpg)
First video[Halo looking sus POV ]

Halo Mega Bloks ODST Hawk (ToysRus Exclusive) Review

MW4 Mercs Mutiplayer Part 1 12-04-10

Halo Reach Legendary Walkthrough: Mission 1 - Winter Contingency

Kwan Ha finds the mystics in the desert #HALO #masterchief #madrigal #thecovenant #haloring

Ghost Recon Future Soldier PS3 - Sand Storm post 1.02 patch (gameplay commentary)

Metro: Last Light Redux — Прохождение Часть - 7: Сквозь Тьму.

Max Payne 1 - Parte 3, Capítulo 6 (Gameplay en Español) (Parte 23/25)

Max Payne 2 The Fall of Max Payne Gameplay Walkthrough Part 3 End
За каждым успешным каналом стоит личность, идея и сотни часов кропотливого труда. Если вы здесь, значит, автор «Скрытые миссии игры» уже сумел зацепить ваше внимание своим уникальным стилем или подачей. А мы на RUVIDEO позаботились о том, чтобы вы могли изучить весь архив его работ в максимально комфортных условиях — без лишней суеты и преград.
Почему за работами канала «Скрытые миссии игры» так интересно наблюдать? Всё просто: это честный контент, который находит отклик в сердцах зрителей. На нашем ресурсе вы можете смотреть онлайн все видео любимого автора бесплатно и в хорошем качестве. Нам важно, чтобы вы видели каждую деталь и слышали каждый нюанс, поэтому мы используем только стабильные плееры из открытых источников Rutube.
Следите за новинками канала, пересматривайте старые шедевры и открывайте для себя новые грани творчества «Скрытые миссии игры». Мы постоянно обновляем ленту, чтобы у вас под рукой всегда были самые свежие выпуски. Никаких сложных регистраций — только вы и творчество, которое вдохновляет. Приятного вам путешествия по миру авторского контента на RUVIDEO!
Видео взято из открытых источников Rutube. Если вы правообладатель, обратитесь к первоисточнику.